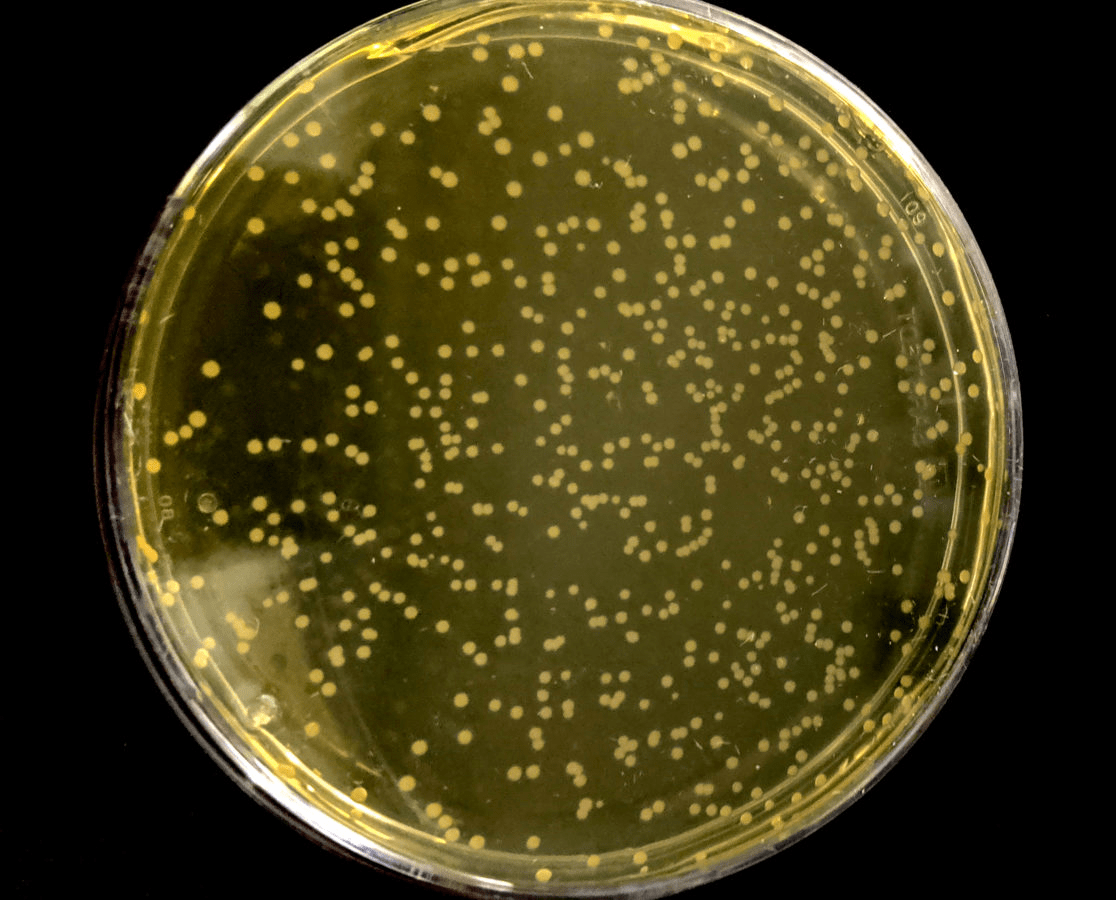
Syn61 — «перекодированная» E. coli

Фантасты в лабораторных халатах: как безумные идеи превратились в бизнес будущего
25 ноября 2025
Фантасты в лабораторных халатах: как безумные идеи превратились в бизнес будущего
- 184
- 0
- 1
Когда воображение перестает быть шуткой — и мамонт из мечты выходит в лабораторию.
-
Автор
-
Редакторы
Статья на конкурс «Био/Мол/Текст»: Науку и бизнес часто разводят по разным берегам: прикладные исследования есть, но прямой маршрут от открытия к инвестициям редок. Есть ли исключения? Можно ли превратить научное исследование в бизнес? Истории таких компаний, как Constructive.Bio, перепрограммировавшей геном прокариот; Colossal Biosciences, работающей над воссозданием видов; и ISMO Bio-Photonics, смоделировавшей легкие на микрочипе, показывают, что можно. О том, на основе каких идей удалось построить эти стартапы и на какие научные концепции они опирались, читайте в этой статье.
Конкурс «Био/Мол/Текст»-2025/2026
Эта работа опубликована в номинации «Академия & Бизнес» конкурса «Био/Мол/Текст»-2025/2026.

Генеральный партнер конкурса и партнер номинации — международная инновационная биотехнологическая компания BIOCAD.

«Книжный» спонсор конкурса — «Альпина нон-фикшн»
Новая стратегия успеха
Мало кто, планируя поступать учиться на исследовательскую профессию, мечтает продавать оборудование или заниматься маркетингом. Все мечтают делать открытия, которые изменят мир. Однако те, кто выдерживает проверку временем, огнем и водой и остается в науке, понимают, что в большинстве случаев ученому придется придерживаться той стратегии, которая приводит лабораторию к получению финансирования и поддерживает ее на плаву.
Старшие исследователи нередко становятся скептиками и не принимают экстремально новые и противоречащие всему уже открытому идеи, предпочитая аккуратно вписываться в рамки предложенных государством грантовых программ.
Однако известны случаи, когда именно прорывные «бредовые» научные идеи привели исследователей и к большим открытиям, и к успешному бизнесу. однако эти истории не служат универсальной инструкцией. За каждой из них стояли не только смелость и авантюризм, но и высокий интеллект, солидные научные навыки, образование и деловая хватка. Сочетание этих факторов, а не просто «следование мечте», делало успех возможным.
Как и у кого получилось построить бизнес на научном открытии? Давайте разбираться!
Наука, которой не верили
Исследователь всегда обязан быть скептиком. Студентов естественнонаучных специальностей учат: «Когда читаете статью, сосредоточьтесь не на том, что в ней сделано правильно и хорошо, а на том, что сделано не так и можно подвергнуть сомнению. Именно это поможет вам наработать критическое мышление и в будущем понимать, какие идеи достойны реализации, а какие — пустышка».
Это абсолютно логично, что каждая мысль, каждое слово в научной работе должно подвергаться очень жесткому анализу и критике. Если отключить скептицизм, неизбежно получится море странных идей, которые будут оголтело стремиться реализовывать «безумные ученые» без оглядки на здравый смысл и логику.
Каждая исследовательская работа проходит несколько «фильтров скептицизма»: сначала при подаче заявки на грант, чтобы ее выполнить; потом в спорах и дискуссиях коллег, ее выполняющих; затем при подаче статьи в научный журнал; и, наконец, при обсуждении научным сообществом того, что было сделано.
Однако периодически все же случается так, что такой полезный и нужный в работе ученых скепсис душит ростки настоящей революции.
Так, в начале 2010-х CRISPR воспринимали скорее как неожиданный иммунологический курьез бактерий, чем как будущую универсальную систему редактирования генома — скепсис сохранялся до тех пор, пока не стало очевидным, что механизм можно перепрограммировать для точных генетических модификаций [1].
- CRISPR-Cas
- — естественная система иммунной защиты бактерий и архей от вирусов, которая работает как «молекулярная память» и «молекулярные ножницы» одновременно: фрагменты вирусной ДНК сохраняются в геноме микроба в виде коротких CRISPR-повторов, а специальные белки Cas, ориентируясь на РНК-копии этих записей, распознают и разрезают чужеродный генетический материал при повторной атаке [2].
Похожая ситуация сложилась и с разработкой неканонических (неприродных) аминокислот Джейсоном Чином, которая вообще считалась химическим курьезом [3], [4]… Но об этом подробнее мы поговорим чуть позже.
Эти проекты в итоге не остались незамеченными — за CRISPR Эмманюэль Шарпантье и Дженнифер Дудна в 2020 году получили Нобелевскую премию [5]. Однако сколько таких гениальных работ осталось незамеченными? Как научному сообществу в будущем избежать зашоренности и перестать отбрасывать революционные идеи, посчитав их слишком фантастическими?
Тут на помощь приходит бизнес. Предприниматель мыслит совершенно не так, как ученый. Он смотрит на идею через призму ее реализуемости и рынка. Именно такая оценка идеи или разработки зачастую помогает ей выжить, «выйти в люди» и сделать это эффектно и с большой финансовой выгодой.
Как это происходит, мы увидим на нескольких ярких примерах коммерческого успеха научных разработок.
История первая: Constructive.Bio — компания, которая решила переписать генетический код
Генетический код универсален для всех живых организмов Земли. Это свод правил, по которым последовательность кодонов (генов и РНК) переводится в последовательность аминокислот (белков). Гипотезы о его происхождении включают в себя стереохимическую модель [6] (связь триплетов с физико-химическими свойствами аминокислот) и коэволюционный сценарий, в котором генетический код развивался параллельно с формированием метаболических путей.
Джейсон Чин решился оспорить представление о генетическом коде как о жестко фиксированной системе. Идея звучит революционно, однако важно заметить, что концепция ортогональных систем трансляции [7] обсуждалась давно. Такие схемы предполагают существование «параллельного словаря», который не конфликтует с клеточным аппаратом, но позволяет встраивать в белки «ненатуральные» аминокислоты.
Такая система использует собственные тРНК и ферменты аминоацил-тРНК-синтетазы [8], которые не пересекаются с «основным» клеточным аппаратом синтеза белка. Благодаря этому в клетке можно создать второй слой трансляции — как бы дополнительный словарь, в котором часть «освобожденных» кодонов имеет новые значения. Таким образом ортогональные системы позволяют расширить язык белкового синтеза, не ломая существующий код, а добавляя к нему еще один, независимый уровень.
В 2019 году в журнале Nature вышла работа Джейсона Чина [9], выполненная в Лаборатории молекулярной биологии Совета по медицинским исследованиям Великобритании (MRC LMB). Исследователи полностью перекодировали геном бактерии (рис. 1). Как им это удалось?
Эти бактерии, которые спокойно едят, размножаются и дышат в маленьких пластиковых чашках с питательным бульоном в лаборатории Джейсона Чина под Лондоном, выглядят совершенно обычно — но отличаются от всех остальных живых существ на Земле, от грибов и авокадо до тюльпанов, дроздов и слонов. Они используют другой генетический код — и при этом прекрасно себя чувствуют.
Рисунок 1. Syn61 — штамм бактерий E. coli с «перекодированным» геномом, растущий на агаровой чашке.
У работы Чина изначально было две цели: он хотел проверить, действительно ли все синонимичные кодоны необходимы, а также создать основу для синтеза in vivo генетически кодируемых неканонических биополимеров.
Для этого он подобрал такую схему перекодирования, при которой его E. coli остались живыми и активными, хотя использовали 59 кодонов вместо природных 61 для всех 20 аминокислот и два кодона вместо трех — для сигнала «стоп». Он и его команда систематически заменили каждое вхождение серинового кодона TCG на AGC; каждое (тоже кодирующее серин) — на AGT; а стоп-кодон TAG — на TAA, всего 18214 замен (рис. 2). Ученые спроектировали три версии «переписанного» генома E. coli, но жизнеспособной оказалась лишь одна — та, что получила имя Syn61.Δ3A.

Рисунок 2. Замена «избыточных» кодонов, кодирующих одни и те же аминокислоты, более экономным набором. В диком типе (wild-type genome) серин кодируется шестью кодонами (TCG, TCA, TCT, TCC, AGT, AGC), а сигнал «стоп» — тремя (TGA, TAA, TAG). В процессе «сжатия» синонимичных кодонов (synonymous codon compression) два сериновых кодона (TCG и TCA) и один стоп-кодон (TAG) были исключены и заменены эквивалентными (AGT/AGC и TAA). В результате был создан «перекодированный» геном (recoded genome), использующий 59 кодонов вместо природных 61 — без потери функциональности клетки.
Работа эта в научном сообществе произвела сильное впечатление. Однако и сомнений было очень много. Одни утверждали, что такое перекодирование генома может отрицательно сказаться на стабильности РНК, транскрипции, трансляции и взаимодействии белков [10], другие сомневались в экологической, функциональной и биоиндустриальной совместимости Syn61 с остальным биомиром [11]. Однако Чин оказался не из робких.
Недолго думая, он создал на основе своего открытия бизнес. Сегодня его спин-офф Constructive.Bio — стартап, который создает устойчивые к вирусам бактерии для технологических производств и новые белки с неканоническими аминокислотами. Новые белки могут нести программируемые новые свойства — например, иметь дополнительные функциональные группы, метки, фоточувствительные участки, быть более стабильными или участвовать в специфических реакциях.
Его запуск сопровождался начальным финансированием (seed round) на сумму около $15 млн и лицензионным соглашением с MRC на использование интеллектуальной собственности группы Чина.
MRC (Medical Research Council) — это Британский Совет по медицинским исследованиям: государственная организация, финансирующая фундаментальные и прикладные исследования в биомедицине. Когда лаборатория Джейсона Чина создала технологию перекодирования генома, права на эти разработки принадлежали MRC. Чтобы использовать их коммерчески, стартап Constructive.Bio получил лицензию от MRC — то есть, официальное разрешение применять эти технологии (патенты, методы, штаммы) в своих продуктах и исследованиях.
В сентябре 2024 компания объявила закрытие раунда Series A на 58 миллионов долларов, что увеличило общий объем привлеченных средств до ~75 миллионов долларов. В марте 2025 компания получила грант от Innovate UK на проект по производству терапевтических пептидов (например, аналогов семаглутида).
Стартап пока что только идет к коммерческому успеху, но благородные идеи компании звучат более чем актуально для современного общества: «Наша миссия — стимулировать инновации, создавая биополимеры, которые прокладывают путь к процветающему и устойчивому будущему».
Опыт Чина доказывает всем скептикам, что фантазии все же воплощаются в жизнь, даже если это мечта о том, чтобы построить новую жизнь.
История вторая: ISMO Bio-Photonics — когда кусочек тела помещается на стекло
Идея создания «органа-на-чипе» не нова — работы на эту тему начали появляться еще в 2010-х годах [12]. Когда микрофлюидные платформы соединяют с трехмерными клеточными культурами, появляется возможность воспроизводить перемещение жидкостей — от условной «крови» до питательных сред — и задавать ткани реальные физические стимулы, вроде ритмичного сокращения или легкого сдвига потока.
Внутри таких платформ (чипов) размещают несколько клеточных слоев, выстраивая их так, чтобы между ними сохранялась передача сигналов через тонкую пористую мембрану. В итоге получается мини-орган: компактная объемная система, где одновременно идут разные биологические процессы, почти как в живой ткани. Подробнее об этом можно почитать в статьях «Органы-на-чипе: когда технология сплетается с жизнью» [13] и «Органы из лаборатории» [14], опубликованных на «Биомолекуле».
В июне же 2025 года в журнале Science вышла статья, в которой исследователи утверждали, что создали «биомиметическую микросистему, которая воссоздает ключевой функциональный альвеолярно-капиллярный интерфейс человеческого легкого» (рис. 3) [15]. Если говорить более простыми словами, то они сконструировали модель человеческого легкого на чипе — с помощью такой конструкции удобно изучать ответ органа на бактерии и воспалительные цитокины, не привлекая к исследованию человека в качестве испытуемого. Безопасно, быстро, удобно. В отличие от ранних моделей, которые имитировали лишь растяжение или барьерную функцию, в этой работе впервые показано, что биомеханика вдоха, альвеолярно-капиллярный барьер и ответ на бактерии действуют совместно.

Рисунок 3. Миниатюрное устройство «легкое-на-чипе» сделано из прозрачного эластичного полимера и содержит крошечные каналы, разделенные тонкой гибкой мембраной, покрытой компонентами внеклеточного матрикса. (а) Когда в боковых камерах создается вакуум, мембрана слегка растягивается — так же, как альвеолы при вдохе, — и устройство начинает имитировать дыхательные движения человеческого легкого. (б) При вдохе в живом легком сокращение диафрагмы снижает внутриплевральное давление (Pip), вызывая расширение альвеол и механическое растяжение альвеолярно-капиллярного интерфейса.
Сначала казалось, что идея «органов-на-чипе» — это настоящая научная фантастика: искусственные легкие, печень или почки в микроскопических каналах, на которых ученые будут проводить эксперименты. В голове сразу возникают образы мини-органов-конструкторов для LEGO — и совершенно справедливо: настоящее ускорение технологии началось с того, что исследователи взялись за индуцированные плюрипотентные стволовые клетки [16]. Их масса напоминает огромную кучу LEGO-блоков, которая будет сама себя собирать, если ее «полить» нужными факторами.
Методы тканевой инженерии позволяют не просто вырастить отдельные кусочки ткани, а формировать многослойные трехмерные структуры с разными типами клеток, межклеточными связями, динамикой жидкостей и внешними физическими стимулами. Об этом довольно увлекательно рассказано в статье «От эксперимента до индустрии: как органоиды строят мост между наукой и бизнесом» [17], победившей в конкурсе «Био/мол/текст» в 2025 году, и в статье «Тканевая инженерия и что она может предложить сегодня» [18].
«Орган-на-чипе» перестает быть просто микрофабрикатом: он становится объемной подобной живой системой, где одновременно движутся потоки жидкости, осуществляется внешняя и внутренняя передача сигналов — почти как в настоящем организме.
Микрофлюидные платформы позволяют воспроизводить ключевые функции человеческих тканей без участия животных [19]: контролировать движение жидкостей, выстраивать барьеры, имитировать дыхание, сердечные сокращения или перистальтику. Это безопасные, этичные и гораздо более предсказуемые тест-системы, где исследователь управляет каждым параметром среды. Особенно хорошо актуальность такого биологического инструмента показала пандемия COVID-19. Миру были отчаянно нужны модели для быстрого тестирования лекарств, и органы на чипе оказались как нельзя кстати.
Технология не ограничилась научной средой. В 2021 году в Индии команда ISMO Bio-Photonics превратила университетскую идею в бизнес-план — и теперь сотрудничает с фармкомпаниями. Стартап был основан Икрамом Ханом во время пандемии на базе Индийского института технологий Мадраса. Основной целью Хана было создание чипов, на которых можно было бы имитировать реакции живых тканей на фармпрепараты, сокращая время и стоимость разработки лекарств.
Бизнес оценил идею, и стартап был достойно профинансирован — он получил гранты от BIRAC, Startup India, IIT Madras incubation cell, а кроме того еще и «ангельские» инвестиции на сумму 120 тыс. долларов.
История ISMO Bio-Photonics — яркий пример того, как наука ушла из чистой лаборатории в предпринимательство, начав измерять успехи не только публикациями, но и коммерческими результатами. Примечательно, что ISMO — не первый бизнес такого рода: еще в 1970-х годах, с появлением Genentech, биотехнологии начали трансформироваться в отрасль, где генетическая инженерия и бизнес-императив шли рука об руку.
История третья: Colossal Biosciences — компания, которая решила воскресить мамонта
Машина времени все же существует? Кажется, скоро и она появится на свет. Ученые смеялись над намерением Джорджа Чёрча «воскресить» мамонта (рис. 4), а потом он получил сотни миллионов инвестиций и основал компанию Colossal Biosciences.

Рисунок 4. Потенциальный воскрешенный мамонт. «Для многих это существо исчезло навсегда. Но не для наших ученых и не для лабораторий нашей компании. Мы уже работаем над возвращением шерстистого мамонта: наши команды собрали жизнеспособные образцы ДНК и редактируют гены, которые позволят этому великолепному представителю мегафауны снова прогреметь по просторам Арктики» — гремят в своих пресс-релизах Colossal.
Воскрешение видов Colossal рассматривает не просто как клонирование «приветов из прошлого», а как инструмент для будущего. Некоторые исчезнувшие виды играли ключевую роль в экосистемах: поддерживали структуру ландшафта, регулировали растительность, помогали сохранять замерзшие почвы и баланс углерода. Их возвращение — это попытка восстановить утраченные экологические функции, которые делают природные системы более устойчивыми к стрессовым факторам.
Про Чёрча с самого начала публиковали критические статьи, заголовки которых сквозили жесткой научной иронией. «Как клонирование мамонта превратилось в фейковую новость: Джордж Чёрч, искусственные матки, эмбрионы слонов — и доверчивые научные СМИ». Мало кто верил в успех идеи, и тем более в успех стартапа.
Какую же технологию планирует использовать Чёрч? Все выглядит довольно логично [21].
Работа над «возвращением» мамонта начинается с фибробластов азиатского слона — крепких, легко выращиваемых клеток кожи, которые служат удобной основой для редактирования генома. В их ДНК с помощью CRISPR-Cas9 проводят точечный «генетический монтаж»: Cas9 делает разрез в выбранных локусах, направляемый гидовыми РНК, а донорные последовательности с мамонтовыми вариантами генов (которые уже расшифрованы [22]) — отвечающих за шерстистость, терморегуляцию, метаболическую устойчивость к холоду и адаптацию к низким температурам — встраиваются по механизму репарации разрыва, после чего клетки проходят повторный отбор, чтобы получить чистую линию без побочных мутаций.
Затем такие отредактированные фибробласты перепрограммируют в индуцированные плюрипотентные стволовые клетки (ИПСК) [23], используя факторы Яманаки и фактически возвращая взрослую клетку в эмбриональное состояние, из которого она снова способна дать начало любой ткани.
На следующем шаге эти ИПСК организуют в эмбрионоподобную структуру и выращивают в искусственной матке — сложной биореакторной системе, которая обеспечивает контролируемую перфузию питательных сред, подачу кислорода, механические и гормональные сигналы и имитирует функции плаценты. В такой управляемой среде формируется зародыш гибридного слона с внедренными мамонтовыми адаптациями — первый шаг к созданию организмов, способных существовать в условиях арктической экосистемы.
В 2025 году Colossal Biosciences представила генетически модифицированных мышей с шерстистым покровом и улучшенным обменом веществ — так называемых «шерстистых мышей», созданных редактированием семи генов. Они не просто носят декоративную «шерсть», а служат платформой-прототипом: они позволяют проверить комплексные инженерные комбинации генов, прежде чем переходить к крупным видам (рис. 5).

Рисунок 5. Шерстистая мышь, созданная компанией Colossal с использованием мультигенного редактирования (слева), рядом с обычной лабораторной мышью (справа). Модель служит прототипом для тестирования генов холодовой адаптации, необходимых для проекта по воссозданию мамонта.
Несмотря на насмешки критиков, Colossal Biosciences привлела очень крупные инвестиции в размере 200 миллионов долларов при оценке в 10,2 миллиарда. Кроме того, компания уже породила спин-офф: Form Bio.
Эта биотехнологическая компания использует искусственный интеллект, биоинформатику и современные методы молекулярной и клеточной биологии, чтобы ускорять развитие генетической медицины и технологий геномного редактирования. Их платформы помогают проектировать и оптимизировать генетические конструкции, повышать безопасность и эффективность систем доставки (например, вирусных векторов), а также переносить достижения геномной инженерии в сферу человеческой медицины. Form Bio также привлекла неплохие инвестиции в начале своей работы.
Новая компания Form Bio привлекла $30 млн в раунде Series A под руководством JAZZ Venture Partners, чтобы дать исследователям в области наук о жизни полноценную платформу для работы с большими наборами данных: управления ими, запуска проверенных аналитических пайплайнов, визуализации результатов и совместной работы с коллегами — фактически устраняя разрыв между данными и научными открытиями.
Так ли важно, получится ли у Чёрча сделать именно мамонта? Кажется, что нет. Важно, что его, казалось бы, безумные идеи , служат мощным драйвером исследований, продвигают технологии и поднимают важные вопросы об экологии — например, о восстановлении утраченных экосистем и их функций, о роли крупных травоядных в климатической устойчивости тундры, о допустимости генной инженерии в сохранении природы, об ответственности за возможные экологические последствия и о том, как безопасно интегрировать биотехнологии в программы восстановления биоразнообразия.
Не так давно ученые из Colossal объявили, что воссоздали лютоволка [25]. Лютый волк был отдельным видом, когда-то населявшим Северную Америку, и его возрождение стало вехой для движения по предотвращения вымирания видов. Лютоволк у всех на слуху благодаря Дж. Мартину. В эпопее «Песнь льда и пламени», а затем и сериале «Игра престолов» эти звери стали одним из самых узнаваемых символов мира Вестероса. У Мартина лютоволк — тотем дома Старков; но в лаборатории — это набор последовательностей, где каждая вставка и делеция влияют на воссоздание вида. Поп-культурный образ помогает привлечь внимание, но научная часть — это скрупулезная инженерия генома и долгие полевые испытания.
Невидимый мост: от академии к стартапу
Академия все чаще и чаще разрабатывает инновационные прикладные решения. Раньше, если говорить о биологии и медицине, они по большей части были направлены на клинику. Но последнее время появляется интерес и к внедрению в более широкий индустриальный и технологический контекст. Однако есть условия, без которых научная идея никогда не сможет стать бизнесом.
Исследовательская гипотеза должна превратиться в ценностное предложение — только так исследователь сможет сместить фокус внимания на то, чем ваша идея может быть полезна миру. Гипотеза может быть отстраненной и сфокусированной сама на себе. Ценностное предложение изначально заточено на то, чтобы принести пользу и деньги. А без этого в бизнесе никуда.
Финансовое мышление тоже придется менять: от идеи «получить грант» нужно переходить к пониманию венчурной модели. Государственные гранты поддерживают в основном аккуратные, предсказуемые исследования — те, что укладывается в рамки госзаказа и экспертного консенсуса. Революционным замыслам там действительно почти нет места: попробуйте подать заявку на «создание нового вида животных» — и академические коллеги лишь удивленно поднимут брови. А вот венчурный инвестор, напротив, ищет идеи с высоким риском и высоким потенциалом — и такие проекты вполне могут оказаться именно тем, что привлечет его внимание .
О том, как инновационные разработки выводятся на фармацевтический рынок через сотрудничество ученых, стартапов, корпораций, пациентских сообществ и государственных организаций, подробно рассказано в спецпроекте «Биомолекулы» «Открытые инновации».
Наконец, ученые должны сами пересмотреть собственную роль. Речи о том, чтобы сменить стремление к научной добросовестности и достоверности на финансовый фокус не идет. Но важно думать не только о том, насколько качественно выполнено исследование и красиво выстроена гипотеза, но и о том, как построить стратегию развития идеи так, чтобы она была жизнеспособна.
После публикации своей работы в Nature [9], Джейсон Чин не ограничился академическим признанием. Он запустил Constructive.Bio, что стало редким примером, когда ученый превратился в предпринимателя, сохранив при этом строгие академические стандарты.
Финал: где кончается фантастика и начинается будущее
Похоже, некоторые исследователи все же смогли вплотную подойти к границе научной фантастики. Кто-то разве верил, геном можно будет синтезировать [26–28] и перепрограммировать [29]? Некоторые планы пока остаются в мечтах — шерстистого мамонта мы только ожидаем. Но вот шерстистая мышь уже увидела свет, значит, результат не за горами.
Радикальные идеи в 21 веке перестали ждать одобрения Nature и Science — продолжая публиковаться в престижных журналах, ученые находят инвестора и воплощают мечты в жизнь. Мир стартапов все плотнее соприкасается с академической наукой — и на стыке этих двух сред действительно возникает новая зона ускоренной эволюции технологий: место, где рискованные научные гипотезы быстро превращаются в работающие прототипы новых биотехнологических платформ — от диагностических систем и микрочипов до генетических конструкций, клеточных линий и экспериментальных терапий, а лабораторные идеи проходят проверку реальным рынком.
Каков будет следующий шаг, никто не знает — возможно, появятся компании, которые создают новые формы жизни, как когда-то фантасты создавали новые миры. Остается лишь с интересом наблюдать!
Литература
- CRISPR-эпопея и ее герои;
- Просто о сложном: CRISPR/Cas;
- Ellen C Minnihan, Kenichi Yokoyama, JoAnne Stubbe. (2009). Unnatural amino acids: better than the real things?. F1000 Biol Rep. 1;
- Daniel L. Dunkelmann, Sebastian B. Oehm, Adam T. Beattie, Jason W. Chin. (2021). A 68-codon genetic code to incorporate four distinct non-canonical amino acids enabled by automated orthogonal mRNA design. Nat. Chem. 13, 1110–1117;
- РНК, ножницы, геномы: объявлены лауреаты Нобелевской премии по химии 2020;
- У истоков генетического кода: родственные души;
- Слово из четырёх букв;
- Heinz Neumann, Adrian L. Slusarczyk, Jason W. Chin. (2010). De NovoGeneration of Mutually Orthogonal Aminoacyl-tRNA Synthetase/tRNA Pairs. J. Am. Chem. Soc. 132, 2142–2144;
- Julius Fredens, Kaihang Wang, Daniel de la Torre, Louise F. H. Funke, Wesley E. Robertson, et. al. (2019). Total synthesis of Escherichia coli with a recoded genome. Nature. 569, 514–518;
- Miguel Angel Martínez, Ana Jordan-Paiz, Sandra Franco, Maria Nevot. (2019). Synonymous genome recoding: a tool to explore microbial biology and new therapeutic strategies. Nucleic Acids Research. 47, 10506–10519;
- Benjamin A. Blount, Tom Ellis. (2019). Construction of an Escherichia coli genome with fewer codons sets records. Nature. 569, 492–494;
- Organ-on-a-chip — Elsevier, 2020;
- Органы-на-чипе: когда технология сплетается с жизнью;
- Органы из лаборатории;
- Dongeun Huh, Benjamin D. Matthews, Akiko Mammoto, Martín Montoya-Zavala, Hong Yuan Hsin, Donald E. Ingber. (2010). Reconstituting Organ-Level Lung Functions on a Chip. Science. 328, 1662–1668;
- Желудок размером с горошину + человеческий кишечник, выращенный в мыши;
- От эксперимента до индустрии: как органоиды строят мост между наукой и бизнесом;
- Тканевая инженерия и что она может предложить сегодня;
- Chak Ming Leung, Pim de Haan, Kacey Ronaldson-Bouchard, Ge-Ah Kim, Jihoon Ko, et. al. (2022). A guide to the organ-on-a-chip. Nat Rev Methods Primers. 2;
- De-extinction: digital lab tech supports a mammoth project. (2023). Nature Research Custom;
- Laura DeFrancesco. (2021). Church to de-extinct woolly mammoths. Nat Biotechnol. 39, 1171–1171;
- Eleftheria Palkopoulou, Swapan Mallick, Pontus Skoglund, Jacob Enk, Nadin Rohland, et. al. (2015). Complete Genomes Reveal Signatures of Demographic and Genetic Declines in the Woolly Mammoth. Current Biology. 25, 1395–1400;
- Нобелевская премия по физиологии и медицине (2012): индуцированные стволовые клетки;
- Kluger J. (2025). CRISPR Breakthrough: Colossal’s Woolly Mouse Could Pave the Way for Mammoth Revival. Colossal;
- Kluger J. (2025). Colossal Biosciences Reawakens the Dire Wolf: De-Extinction Meets Cutting-Edge Science. Colossal;
- Синтетическая жизнь;
- Синтезировать-невысинтезировать!;
- Синтетическая хромосома;
- Расширенный геном.







Комментарии
0Чтобы оставить комментарий, необходимо
войти